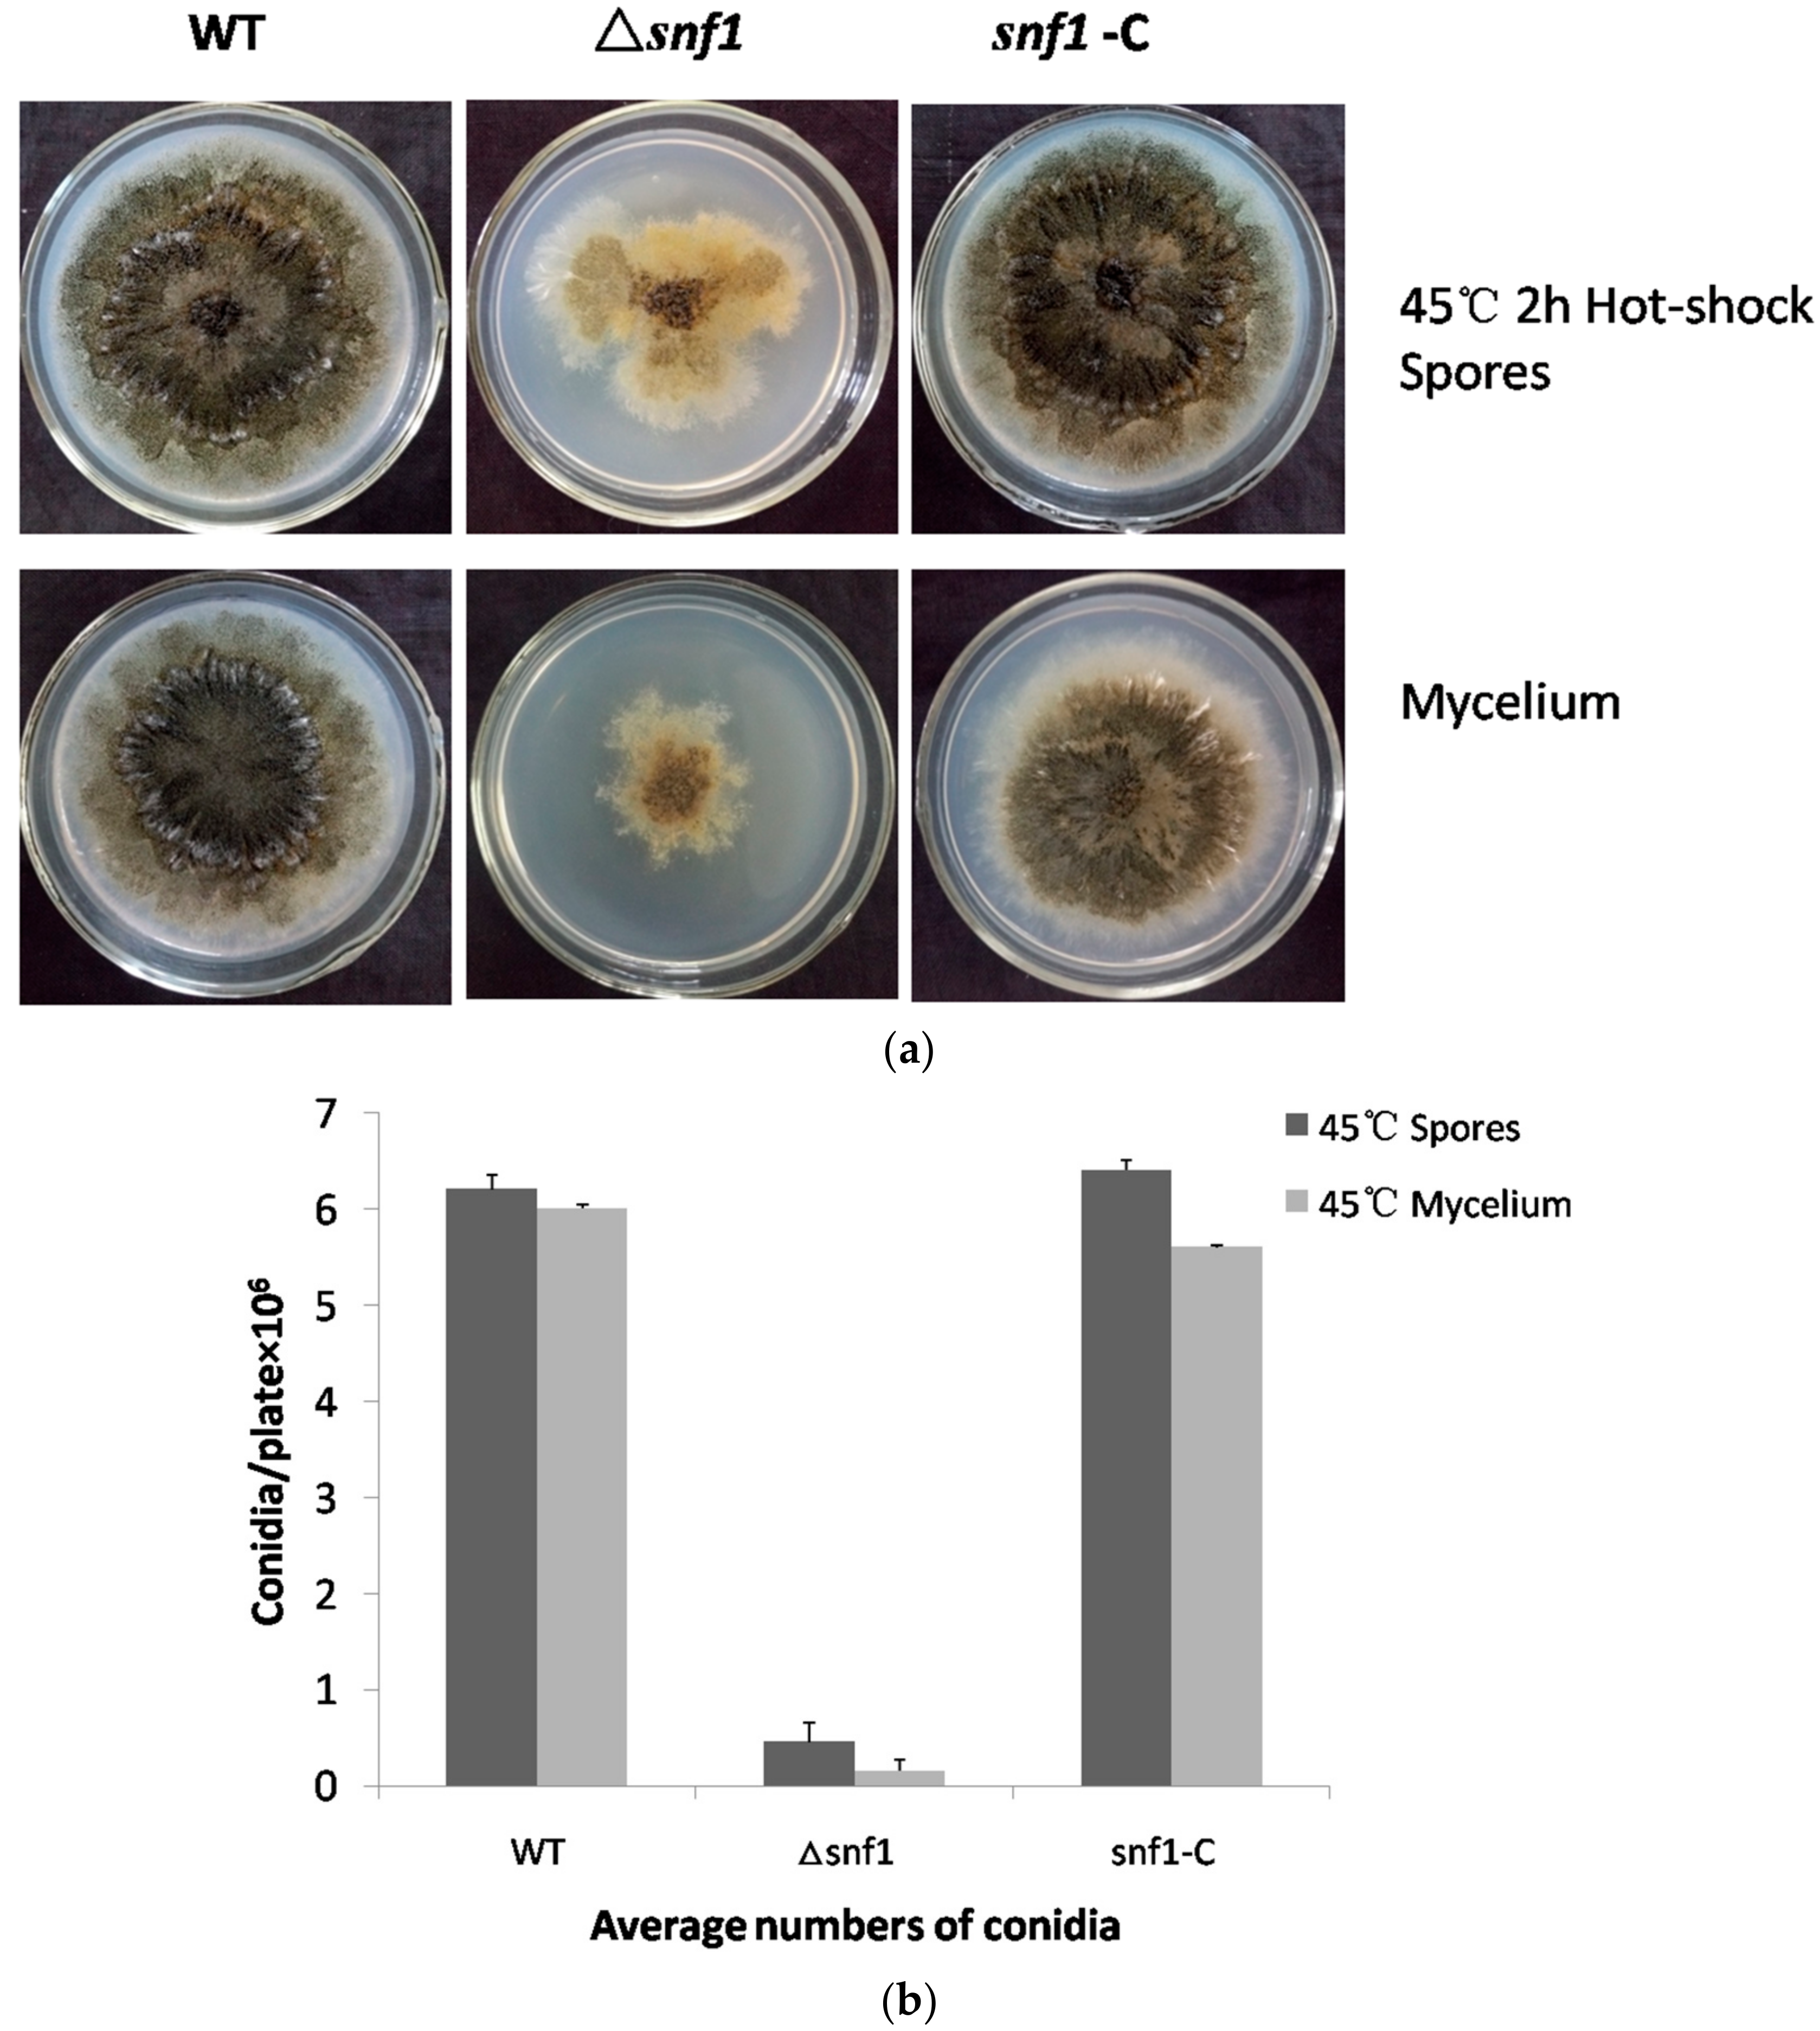
Genes 09 00059 g005

The AMP-Activated Protein Kinase Homolog Snf1 Concerts Carbon Utilization, Conidia Production and the Biosynthesis of Secondary Metabolites in the Taxol-Producer Pestalotiopsis microspora
Abstract
:1. Introduction
2. Materials and Methods
2.1. Strains and Culture Conditions
2.2. Construction of snf1 Mutant and Complemented Strains
2.3. Analysis of snf1 Roles on Carbon Source Utilization
2.4. Quantification of Conidia Production and Mycelia
2.5. Heat Tolerance Assay
2.6. Phenotype Observation and Secondary Metabolite Profiling for Δsnf1
2.7. Drug and Stress Sensitivity Assays
3. Results
3.1. Characterization of snf1 Homolog in Pestalotiopsis microspora
3.2. Snf1 Is Necessary for Conidiation, Colonial Pigmentation and Vegetative Growth
3.3. Requirement of snf1 for Utilization of Carbon Sources
3.4. Roles of Snf1 in Tolerance to External Stress
3.5. Sensitivity of Δsnf1 to Heat Shock
3.6. Roles of Snf1 in the Biosynthesis of Secondary Metabolites
4. Discussion
5. Conclusions
Acknowledgments
Author Contributions
Conflicts of Interest
References
- Ghillebert, R.; Swinnen, E.; Wen, J.; Vandesteene, L.; Ramon, M.; Norga, K.; Rolland, F.; Winderickx, J. The AMPK/SNF1/SnRK1 fuel gauge and energy regulator: Structure, function and regulation. FEBS J. 2011, 278, 3978–3990. [Google Scholar] [CrossRef] [PubMed]
- Hardie, D.G. AMP-activated/SNF1 protein kinases: Conserved guardians of cellular energy. Nat. Rev. Mol. Cell Biol. 2007, 8, 774–785. [Google Scholar] [CrossRef] [PubMed]
- Hedbacker, K.; Hong, S.P.; Carlson, M. Pak1 protein kinase regulates activation and nuclear localization of Snf1-Gal83 protein kinase. Mol. Cell. Biol. 2004, 24, 8255–8263. [Google Scholar] [CrossRef] [PubMed]
- Kim, M.D.; Hong, S.P.; Carlson, M. Role of Tos3, a Snf1 protein kinase kinase, during growth of Saccharomyces cerevisiae on nonfermentable carbon sources. Eukaryot. Cell 2005, 4, 861–866. [Google Scholar] [CrossRef] [PubMed]
- Nath, N.; McCartney, R.R.; Schmidt, M.C. Yeast Pak1 kinase associates with and activates Snf1. Mol. Cell. Biol. 2003, 23, 3909–3917. [Google Scholar] [CrossRef] [PubMed]
- Sutherland, C.M.; Hawley, S.A.; McCartney, R.R.; Leech, A.; Stark, M.J.R.; Schmidt, M.C.; Hardie, D.G. Elm1p is one of three upstream kinases for the Saccharomyces cerevisiae SNF1 complex. Curr. Biol. 2003, 13, 1299–1305. [Google Scholar] [CrossRef]
- Hong, S.P.; Leiper, F.C.; Woods, A.; Carling, D.; Carlson, M. Activation of yeast Snf1 and mammalian AMP-activated protein kinase by upstream kinases. Proc. Natl. Acad. Sci. USA 2003, 100, 8839–8843. [Google Scholar] [CrossRef] [PubMed]
- Sanz, P.; Alms, A.G.; Haystead, T.A.; Carlson, M. Regulatory interactions between the Reg1-Glc7 protein phosphatase and the Snf1 protein kinase. Mol. Cell. Biol. 2000, 20, 1321–1328. [Google Scholar] [CrossRef] [PubMed]
- Cannon, J.F.; Pringle, J.R.; Fiechter, A.; Khalil, M. Characterization of glycogen-deficient glc mutants of Saccharomyces cerevisiae. Genetics 1994, 136, 485–503. [Google Scholar] [PubMed]
- Huang, D.; Wilson, W.A.; Roach, P.J. Glucose-6-P control of glycogen synthase phosphorylation in yeast. J. Biol. Chem. 1997, 272, 22495–22501. [Google Scholar] [CrossRef] [PubMed]
- Thompson-Jaeger, S.; François, J.; Gaughran, J.P.; Tatchell, K. Deletion of Snf1 affects the nutrient response of yeast and resembles mutations which activate the adenylate cyclase pathway. Genetics 1991, 129, 697–706. [Google Scholar] [PubMed]
- Tamai, K.T.; Liu, X.; Silar, P.; Sosinowski, T.; Thiele, D.J. Heat shock transcription factor activates yeast metallothionein gene expression in response to heat and glucose starvation via distinct signalling pathways. Mol. Cell. Biol. 1994, 14, 8155–8165. [Google Scholar] [CrossRef] [PubMed]
- Bertram, P.G.; Choi, J.H.; Carvalho, J.; Chan, T.F.; Ai, W.; Zheng, X.F.S. Convergence of TOR-Nitrogen and Snf1-Glucose Signaling Pathways onto Gln3. Mol. Cell. Biol. 2002, 22, 1246–1252. [Google Scholar] [CrossRef] [PubMed]
- De Wever, V.; Reiter, W.; Ballarini, A.; Ammerer, G.; Brocard, C. A dual role for PP1 in shaping the Msn2-dependent transcriptional response to glucose starvation. EMBO J. 2005, 24, 4115–4123. [Google Scholar] [CrossRef] [PubMed]
- Mayordomo, I.; Estruch, F.; Sanz, P. Convergence of the target of rapamycin and the Snf1 protein kinase pathways in the regulation of the subcellular localization of Msn2, a transcriptional activator of STRE (Stress Response Element)-regulated genes. J. Biol. Chem. 2002, 277, 35650–35656. [Google Scholar] [CrossRef] [PubMed]
- Hedbacker, K.; Carlson, M. SNF1/AMPK pathways in yeast. Front. Biosci. 2008, 13, 2408–2420. [Google Scholar] [CrossRef] [PubMed]
- Hardie, D.G. AMPK and SNF1: Snuffing out stress. Cell Metab. 2007, 6, 339–340. [Google Scholar] [CrossRef] [PubMed]
- Bi, J.N.; Ji, Y.; Pan, J.; Yu, Y.; Chen, H.; Zhu, X. A new taxol-producing fungus (Pestalotiopsis malicola) and evidence for taxol as a transient product in the culture. Afr. J. Biotechnol. 2011, 10, 6647–6654. [Google Scholar]
- Hao, X.R.; Ji, Y.; Liu, S.R.; Bi, J.N.; Bi, Q.; Pan, J.; Zhu, X. Optimized integration of T-DNA in the taxol-producing fungus Pestalotiopsis malicola. Afr. J. Biotechnol. 2012, 11, 771–776. [Google Scholar]
- Niu, X.; Hao, X.; Hong, Z.; Chen, L.; Yu, X.; Zhu, X. A putative histone deacetylase modulates the biosynthesis of Pestalotiollide B and conidiation in Pestalotiopsis microspora. J. Microbiol. Biotechnol. 2015, 25, 579–588. [Google Scholar] [CrossRef] [PubMed]
- Wang, D.; Akhberdi, O.; Hao, X.; Yu, X.; Chen, L.; Liu, Y.; Zhu, X. Amino acid sensor kinase Gcn2 is required for conidiation, secondary metabolism, and cell wall integrity in the taxol-producer Pestalotiopsis microspora. Front. Microbiol. 2017, 8, 1879. [Google Scholar] [CrossRef] [PubMed]
- Chen, L.; Wei, D.; Zhang, Q.; Yu, X.; Wang, Y.; Zhu, X. Orotidine 5′-phosphate decarboxylase-based reusable in situ genetic editing system: Development and application in taxol-producing Pestalotiopsis microspora. Eng. Life Sci. 2015, 15, 542–549. [Google Scholar] [CrossRef]
- Chen, L.; Li, Y.; Zhang, Q.; Wang, D.; Akhberdi, O.; Wei, D.; Pan, J.; Zhu, X. Improved pestalotiollide B production by deleting competing polyketide synthase genes in Pestalotiopsis microspora. J. Ind. Microbiol. Biotechnol. 2017, 44, 237–246. [Google Scholar] [CrossRef] [PubMed]
- Calvo, A.M.; Wilson, R.A.; Bok, J.W.; Keller, N.P. Relationship between secondary metabolism and fungal development. Microbiol. Mol. Biol. Rev. 2002, 66, 447–459. [Google Scholar] [CrossRef] [PubMed]
- Young, E.T.; Dombek, K.M.; Tachibana, C.; Ideker, T. Multiple pathways are co-regulated by the protein kinase Snf1 and the transcription factors Adr1 and Cat8. J. Biol. Chem. 2003, 278, 26146–26158. [Google Scholar] [CrossRef] [PubMed]
- Yi, M.; Park, J.H.; Ahn, J.H.; Lee, Y.H. MoSNF1 regulates sporulation and pathogenicity in the rice blast fungus Magnaporthe oryzae. Fungal Genet. Biol. 2008, 45, 1172–1181. [Google Scholar] [CrossRef] [PubMed]
- Yang, J.; Li, D.; Liu, X.; Pan, J.; Yan, B.; Zhu, X. Regulation of virulence factors, carbon utilization and virulence by SNF1 in Cryptococcus neoformans JEC21 and divergent actions of SNF1 between cryptococcal strains. Fungal Genet. Biol. 2010, 47, 994–1000. [Google Scholar] [CrossRef] [PubMed]
- Lipke, P.N.; Ovalle, R. Cell wall architecture in yeast: New structure and new challenges. J. Bacteriol. 1998, 180, 3735–3740. [Google Scholar] [PubMed]
- Ram, A.F.; Klis, F.M. Identification of fungal cell wall mutants using susceptibility assays based on Calcofluor white and Congo red. Nat. Protoc. 2006, 1, 2253–2256. [Google Scholar] [CrossRef] [PubMed]
- Hahn, J.S.; Thiele, D.J. Activation of the Saccharomyces cerevisiae heat shock transcription factor under glucose starvation conditions by Snf1 protein kinase. J. Biol. Chem. 2004, 279, 5169–5176. [Google Scholar] [CrossRef] [PubMed]
- Park, H.S.; Yu, J.H. Genetic control of asexual sporulation in filamentous fungi. Curr. Opin. Microbiol. 2012, 15, 669–677. [Google Scholar] [CrossRef] [PubMed]
- Kato, N.; Brooks, W.; Calvo, A.M. The expression of sterigmatocystin and penicillin genes in Aspergillus nidulans is controlled by veA, a gene required for sexual development. Eukaryot. Cell 2003, 2, 1178–1186. [Google Scholar] [CrossRef] [PubMed]
- Zhang, T.; Sun, X.; Xu, Q.; Zhu, C.; Li, Q.; Li, H. PdSNF1, a sucrose non-fermenting protein kinase gene, is required for Penicillium digitatum conidiation and virulence. Appl. Microbiol. Biotechnol. 2013, 97, 5433–5445. [Google Scholar] [CrossRef] [PubMed]
- Lee, S.H.; Lee, J.; Lee, S.; Park, E.H.; Kim, K.W.; Kim, M.D.; Yun, S.H.; Lee, Y.W. GzSNF1 is required for normal sexual and asexual development in the ascomycete Gibberella zeae. Eukaryot. Cell 2009, 8, 116–127. [Google Scholar] [CrossRef] [PubMed]
- Izumitsu, K.; Yoshimi, A.; Kubo, D.; Morita, A.; Saitoh, Y.; Tanaka, C. The MAPKK kinase ChSte11 regulates sexual/asexual development, melanization, pathogenicity, and adaptation to oxidative stress in Cochliobolus heterostrophus. Curr. Genet. 2009, 55, 439–448. [Google Scholar] [CrossRef] [PubMed]
- Jain, S.; Akiyama, K.; Kan, T.; Ohguchi, T.; Takata, R. The G protein β subunit FGB1 regulates development and pathogenicity in Fusarium oxysporum. Curr. Genet. 2003, 43, 79–86. [Google Scholar] [PubMed]
- Bayram, O.; Braus, G.H. Coordination of secondary metabolism and development in fungi: The velvet family of regulatory proteins. FEMS Microbiol. Rev. 2012, 36, 1–24. [Google Scholar] [CrossRef] [PubMed]

| Primer | Sequence (5′—3′) |
|---|---|
| Snf1-up(F) | GGGGACAGCTTTCTTGTACAAAGTGGAA TCATCAGGCTCGTTATTG |
| Snf1-up(R) | GGGGACTGCTTTTTTGTACAAACTTGT GTAGGTTCTCGGGTTTCA |
| Snf1-down(F) | GGGGACAACTTTGTATAGAAAAGTTGTT AGGCGATTCTATTTCTGT |
| Snf1-down(R) | GGGGACAACTTTGTATAATAAAGTTGT TAACTGCTCGTGTTCTGG |
| Snf1(F) | TTACCGTCCATCCACAAGAT |
| Snf1(R) | AAGGGTCTGGGTGGTATGAT |
| Snf1-PRO(F) | GGGGACAGCTTTCTTGTACAAAGTGGAAATCATACCACCCAGACCCTT |
| Snf1-TER(R) | GGGGACAACTTTGTATAATAAAGTTGT ATCTTGTGGATGGACGGTAA |
| Ura3(F) | CGAGGTCGACATAACTTCGT |
| Ura3(R) | ACGAAGTTATTTCACTGGCA |
| Hyg(F) | GCCCTTCCTCCCTTTATT |
| Hyg(R) | TGTTGGCGACCTCGTATT |
© 2018 by the authors. Licensee MDPI, Basel, Switzerland. This article is an open access article distributed under the terms and conditions of the Creative Commons Attribution (CC BY) license (http://creativecommons.org/licenses/by/4.0/).
Share and Cite
Wang, D.; Li, Y.; Wang, H.; Wei, D.; Akhberdi, O.; Liu, Y.; Xiang, B.; Hao, X.; Zhu, X. The AMP-Activated Protein Kinase Homolog Snf1 Concerts Carbon Utilization, Conidia Production and the Biosynthesis of Secondary Metabolites in the Taxol-Producer Pestalotiopsis microspora. Genes 2018, 9, 59. https://doi.org/10.3390/genes9020059
Wang D, Li Y, Wang H, Wei D, Akhberdi O, Liu Y, Xiang B, Hao X, Zhu X. The AMP-Activated Protein Kinase Homolog Snf1 Concerts Carbon Utilization, Conidia Production and the Biosynthesis of Secondary Metabolites in the Taxol-Producer Pestalotiopsis microspora. Genes. 2018; 9(2):59. https://doi.org/10.3390/genes9020059
Chicago/Turabian StyleWang, Dan, Yingying Li, Haichuan Wang, Dongsheng Wei, Oren Akhberdi, Yanjie Liu, Biyun Xiang, Xiaoran Hao, and Xudong Zhu. 2018. "The AMP-Activated Protein Kinase Homolog Snf1 Concerts Carbon Utilization, Conidia Production and the Biosynthesis of Secondary Metabolites in the Taxol-Producer Pestalotiopsis microspora" Genes 9, no. 2: 59. https://doi.org/10.3390/genes9020059
APA StyleWang, D., Li, Y., Wang, H., Wei, D., Akhberdi, O., Liu, Y., Xiang, B., Hao, X., & Zhu, X. (2018). The AMP-Activated Protein Kinase Homolog Snf1 Concerts Carbon Utilization, Conidia Production and the Biosynthesis of Secondary Metabolites in the Taxol-Producer Pestalotiopsis microspora. Genes, 9(2), 59. https://doi.org/10.3390/genes9020059
